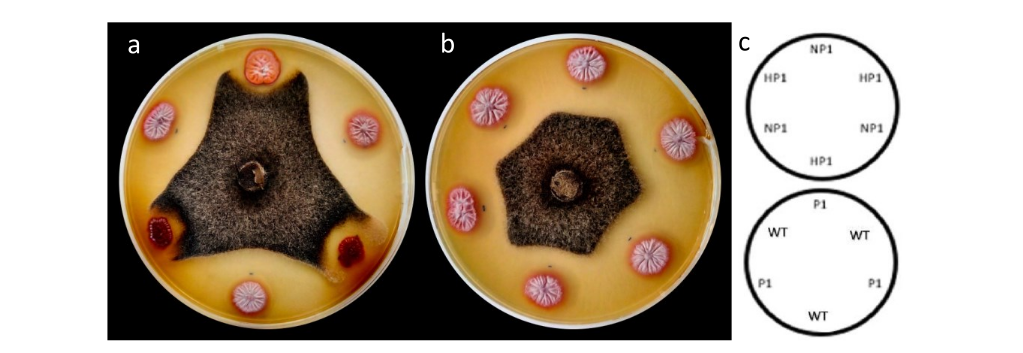
Biological activity assays between Streptomyces 5.1 enhanced and null mutants. Production of antifungal compounds by mutants of the bacterium Streptomyces 5.1 for the control of the phytopathogenic fungus Colletotrichum gloeosporioides, a) non-producer mutants (NP) and enhanced (HP), b) producer mutants (P), c) essay scheme.

Biotecnologia
Evaluation of the production of antifungal metabolites against Colletotrichum gloeosporioides in Streptomyces 5.1 by random mutagenesis
Evaluation of the production of antifungal metabolites against Colletotrichum gloeosporioides in Streptomyces 5.1 by random mutagenesis
Acta Scientiarum. Biological Sciences, vol. 43, e54709, 2021
Universidade Estadual de Maringá

Esta obra está bajo una Licencia Creative Commons Atribución 4.0 Internacional.
Recepción: 09 Julio 2020
Aprobación: 31 Agosto 2020
Abstract: Streptomyces 5.1 is a bacterium isolated from rice soils in the south of the Tolima department (Colombia). This microorganism is characterized by its antagonistic activity against rubber tree phytopathogens like Colletotrichum gloeosporioides, the causal agent of leaf anthracnose. The antifungal activity of this Streptomyces isolate has been associated with secondary metabolites production. However, the identity of those metabolites is unknown because its purification and identification have not been possible through classic chemical studies. Therefore, aiming to contribute in the study of the secondary metabolites produced by 5.1 from a molecular approach, this research seeks to identify -preliminarily- the genomic fingerprint changes associated with the production of antifungal secondary metabolites produced by Streptomyces 5.1 through the evaluation of a mutant library of 5.1 obtained by random mutagenesis using controlled ultraviolet light exposure. The antifungal activity of obtained mutants was evaluated using Colletotrichum gloeosporioides (C1) fungus as a biosensor, isolated by the Biotechnology Institute of Universidad Nacional de Colombia. In this way, the library of mutants of 5.1, initially formed by 300 isolations, was classified into two phenotypic groups of interest: enhanced mutants (1 isolate) and null mutants (11 isolates) of secondary metabolites. The genomic changes in both groups were analyzed by obtaining the genomic profile of the isolates using Repetitive Extragenic Palindromic (Rep-PCR). The obtained profiles evidenced the presence of one additional band in the enhanced mutant, and the absence of a specific band in the non-producing mutants, both in comparison with the original strain. These bands are proposed for a future sequencing study which will define their role in the production process of metabolites with antifungal activity in Streptomyces 5.1.
Keywords: Streptomyces, antifungal bioactive metabolites, Rep-PCR fingerprinting, UV random mutagenesis, biological control.
Introduction
Antagonistic microorganisms have been studied in the last fifty years, due to its potential for controlling phytopathogens on crops with agricultural and economic importance (Serrano-Carreón & Galindo-Fentanes, 2007). These microorganisms can reduce phytopathogen impact on plants through direct and indirect mechanisms (Bloemberg & Lugtenberg, 2001; Hibbing, Fuqua, Parsek, & Peterson, 2010).
Among direct mechanisms, antibiosis has a high potential as a microbial biocontrol mechanism. This mechanism is based on the production of a single or a set of molecules (mostly secondary metabolites) by a microorganism that can inhibit the growth or development of another (susceptible) organism(s) (Vaidya, Shah, Vyas, & Chhatpar, 2001;Garon et al., 2006). This inhibition process is associated with DNA, RNA, proteins synthesis interference, or cell wall destabilization (Vaidya et al., 2001; Gohel et al., 2006).
Regarding the production of antibiotic secondary metabolites, the most studied microorganisms are the members of the Streptomyces genus. These gram-positive bacteria belong to the Actinobacteria phylum (Nandakuma et al., 2009); They are known for their broad secondary metabolism, their typical mycelial-like growth, and their ability to produce spores as propagation mechanisms (Yagüe, López-García, Rioseras, Sánchez, & Manteca, 2012). Their mycelial-like growth allows them to colonize a wide range of ecological niches such as soil, leaves, and rhizosphere of many plants including rice, clovers, soybean, and chickpea (Vurukonda, Giovanardi, & Stefani, 2018). For these reasons, different Streptomyces strains are commonly used as potential biocontrol agents for the management of bacterial, fungal, and oomycetes phytopathogens such as Fusarium spp., Phytophthora spp., and Rhizoctonia spp., as well as several Colletotrichum species (Vinchira-Villarraga et al., 2017; Vurukonda et al., 2018).
From these phytopathogens, Colletotrichum gloeosporioides is of great interest in the biocontrol area due to its wide range of plant hosts (Lieberei, 2007). This fungus, member of the Ascomycota phylum, is present in different tropical zones where it has been reported as the causal agent of leaf anthracnose in plants like natural rubber trees (Cuéllar & León, 2011).
In fact, leaf anthracnose in natural rubber trees has been a major issue in the last decades because of the increasing incidence and wide impact in countries like Colombia and Brazil (Furtado & Trindade, 2005). In Asian and African countries, there are estimations that suggest production lost around 30% per hectares (Guyot et al., 2001;Cai, Li, He, Xiao, & Zhang, 2009). The presence of this phytopathogen has been related to low productivity of rubber trees plantations which leads to countries like Colombia to import this raw material (latex) to supply the inner demand of natural rubber and its derivatives (Lieberei, 2007;Cuéllar & León, 2011).
In this context, different approaches have been evaluated for the management of C. gloeosporioides in rubber crops. These strategies include chemical control chemical pesticides like Acephate, lambda cyhalothrin and thiamethoxam (Brown, Davis, & Ritchter, 2012), cultural techniques (Good Agricultural Practices), and biological control like resource competition, Quorum Quenching and antibacterial metabolites production (Bloemberg & Lugtenberg, 2001; Hibing et al., 2010).
As a part of a bioprospecting program that aimed to find potential bacterial strains that can inhibit the growth of C. gloeosporioides, the Bioprocess and Bioprospecting research group from the Biotechnology Institute of Universidad Nacional de Colombia (IBUN) selected the Streptomyces 5.1 strain from a collection of Actinobacteria-like microorganisms obtained from rhizospheric soil samples. Streptomyces 5.1 demonstrated antifungal activity in previous works on in vitro tests against Colombian virulent C. gloeosporioides strains as well as antibacterial and antifungal activity against several plant pathogens of rice and yam (Suárez-Moreno et al., 2019).
Currently, there is no information about the identity of the secondary metabolites related to the antifungal activity of this bacteria. The bio-guided fractionation proposes to purify and elucidate the antifungal compounds produced by Streptomyces 5.1 was insufficient and did not allow to obtain enough number of pure compounds to do its chemical study. In this context, the present research proposes a molecular approach using random mutagenesis coupled with a Repetitive Extragenic Palindromic (Rep-PCR) fingerprinting protocol in order to study the possible genetic differences induced in enhanced or null mutants of 5.1 aiming to follow the generated mutation and find a possible relationship with the production of bioactive metabolites. The data obtained here will support the identification process of the active compounds produced by Streptomyces 5.1 and will allow to propose methods for scaling-up and monitoring the liquid fermentation of this microorganism.
Material and methods
Streptomyces 5.1 growth and maintenance
Streptomyces 5.1 was originally isolated from rice rhizosphere soil from La Pilar (Venadillo) and El Puente (Armero), both located in the Tolima department, Colombia by the Bioprocesses and Bioprospecting group from the IBUN (Suárez-Moreno et al., 2019). The original wild strain was recovered from a cryopreserved vial, and then grown on ISP3 solid medium (Oatmeal 20 g mL-1, FeSO4.7H2O 0,001 mg mL-1, MnCl2.4H2O 0,001 mg mL-1, ZnSO4.7H2O 0,001 mg mL-1, Agar 18 g L-1). The strain was incubated for 5 days at 30ºC to (i) confirm its macroscopic and microscopic characteristics; (ii) evaluate its antifungal activity against C. gloeosporiodes (as described by Vinchira-Villarraga et al., 2017); and (iii) generate a working inoculum for random mutagenesis (Suárez-Moreno et al., 2019).
Colletotrichum gloeosporioides isolation and characterization
Colletotrichum gloeosporioides (C1) used in this study, was isolated from rubber leaves with advanced anthracnose symptoms from Corpoica´s clonal gardens - La Libertad section, located in Villavicencio in the Mavalle S.A. plantations (Meta department, Colombia). This, C. gloeosporioides (C1) isolation was executed by direct seeding on PDA of anthracnose symptomatic foliage. The isolation, cultures, and initial molecular identification of C1 was done by the natural rubber research line within the Bioprocesses and Bioprospecting group at the IBUN.
The phenotypic characterization confirmed the identity of this microorganism as a member of Colletotrichum genus. After that, the genotypic characterization was performed by sequencing the Internal Transcribed Spacer 1 using the universal primers ITS1 (5’-TCCGTAGGTGAACCTGCGG-3’) and ITS4 (5’‒TCCTCCGCTTATTGATATGC‒3’) (White, Bruns, Lee, & Taylor, 1990). Obtained amplicons were sequenced by duplicate, assembled, and analyzed by BLASTN against GenBank database (Vinchira-Villarraga et al., 2017).
For the antifungal activity test, the fungus was grown in Potato Dextrose Agar (PDA) and incubated for 15 days at 25ºC. The macroscopic and microscopic characteristics of the isolated were verified prior to its use on in vitro tests. The in vitro assays were performed during the first state of infection of C. gloeosporioides with the aim of avoiding virulence loss from the chosen colonies.
Bacterial mutants library construction by random mutagenesis
A random mutagenesis protocol was executed to generate the library of mutants, using ultraviolet light according to the recommendations of Korbekandi et al. (2010). Briefly, 1mL of a suspension of Streptomyces 5.1 (105 UFC mL-1) was deposited into a 9 cm sterile petri dish in constant agitation (90 rpm). To find the best conditions to generate spontaneous 5.1 mutants, the petri dish was located under UV radiation at different distances (between 1 to 30 cm from a UV light bulb) and applying direct and indirect UV exposure (with and without petri dish cover) in three independent assays. The effectiveness of each condition was evaluated by plate count on nutrient agar medium. Only the condition that allowed a survival rate of 0.01 - 0.1% of the original strain concentration was considered as positive and was therefore used as the first step in the construction of the library of mutants. It is important to note that all the experiments were done in darkness to avoid photorepair mechanisms.
Antifungal activity screening of Streptomyces 5.1 mutants
The evaluation of the antifungal activity shown by Streptomyces 5.1 in the wildtype and in the resulting mutants was done by growing a single colony of each mutant sample by triplicate in a PDA medium. Then, a 6 mm disk with mycelium extracted from the phytopathogen fungus culture was then deposited in the center of the plate. After this, plates were incubated for 15 days at 25°C (required time for full fungus growth). The inhibition radius of each mutant was measured in millimeters (mm) as a variable to determine the antifungal activity of mutants and their phenotype.
Statistical differences between the antifungal activity of evaluated mutants were calculated using one-way (p < 0.05) ANOVA with Dunnett's post hoc test for comparing the obtained measures of each mutant with the wildtype strain. This analysis was done according to the antifungal activity of the obtained mutants using GraphPad Prism 5.0 (GraphPad Software, Inc., San Diego, CA), allowing the classifications of mutants into three categories: i) mutants without changes in their antifungal activity, ii) enhanced mutants (those with greater antifungal activity than the wildtype) and iii) null mutants (without antifungal activity).
Genomic profiles of Streptomyces 5.1 mutants
Aiming the analysis of the chosen mutants, the evaluation of genomic profiles of null and enhanced mutants of Streptomyces was proposed using Rep-PCR. For this, three phases were defined to include: DNA extraction, protocol implementation of repetitive sequences amplification (REP) by TouchDown PCR, and statistical analysis from obtained data, as described below.
DNA extraction
The protocol described by Stirling (2003) -with some modifications- was followed for DNA extraction. The biomass of the wildtype strain and its mutants, necessary to obtain their DNA, was obtained growing the wildtype strain and each mutant in triplicate in 15 mL of Luria-Bertani liquid medium for five days at 30°C in darkness and with (90 rpm) constant shaking. Once the incubation time was over, 500 µL of the biomass of each mutant was pipetted in a sterile 2 mL Eppendorf tube; every Eppendorf tube contained around five to seven zircon pearls. Then, the tubes were put inside a BeadBeater as a cell disruption mechanism. Every one of these samples was rehydrated in 700 µL of 2x Cetyltrimethylammonium bromide (CTAB) buffer (4.0 g CTAB), 100 mM Tris (pH 8.0), 20 mM ethylenediamine tetraacetic acid (EDTA), 1.4M NaCl) and incubated at 57ºC for an hour. After that, a Chloroform/Isoamyl Alcohol step was performed for purification. Once the DNA samples were obtained, they were purified employing PureLink™ Genomic DNA Mini Kit Invitrogen (Thermo Fisher Scientific), and finally, they were quantified in triplicate using a NanoDrop® Spectrophotometer ND-1000.
Rep-PCR protocol implementation for genomic profiles obtention
In order to find genomic changes between the wildtype strain and its mutants, a Rep-PCR genotypification protocol was used. BOX-PCR fingerprinting (Malathum, Singh, Weinstock, & Murray, 1998) was selected using primer BOXA1R (5´-CTACGGCAAGGCGACGCTGACG-3´). The amplification reactions were performed in a final volume of 25 µL, containing 1X Buffer, 6 mm MgCl, each primer at 1 µM, dNTPs at 1 mm, 2 U of GoTaq® DNA Polymerase, and 10 of 100% dimethylsulfoxide. Each amplification program started by initial denaturation for 5 min. at 95°C, then 30 cycles of denaturation for 1 min. at 94°C, a gradient for optimization annealing of 1 min. at 50 - 55°C, an extension step of 4 min. at 65°C, and a final extension step of 16 min. at 65°C (Versalovic, Koeuth, & Lupski, 1991;Malathum et al.,1998). According to the previous protocol, genomic changes were shown in a 2.5% Agarose gel dissolved in 1 X TBE buffer and dyed with SYBR® Gold. This gel was placed inside the electrophoresis camera with the buffer (at the same concentration as in the previous process) for two hours at 75 v. The gel was visualized with the Gel Doc™ XR+ Gel Documentation System device through Imagine Lab™ software.
Statistical analysis of the genomic profiles
Once the genomic profiles of the wildtype strain and its mutants were obtained, an incidence table (similarity matrix) for each isolate was generated. The obtained data were analyzed by grouping analysis (UPGMA) using NTSYS ver. 2.2 program with Sorensen-Dice index to evaluate the differences in the number of bands between the wildtype strain and its mutants, as well as the possible correlation with the prospected phenotypic characteristics, which correspond to the formation of red-orange and non-sporulation colonies of Streptomyces 5.1, as null mutants (without antifungal activity).
Results and discussion
Verification of the macro and microscopic characteristics of the wildtype strain Streptomyces 5.1 and its antifungal activity against C. gloeosporioides
Macro and microscopic characteristics of Streptomyces 5.1 and C. gloeosporioides (C1) were verified in order to confirm its antifungal activity (5.1) and virulence (C1). In the case of Streptomyces 5.1, the growth in Luria-Bertani and ISP3 medium was evaluated. In the first medium, it was possible to observe the same size, beige round colonies hardly adhered to medium In ISP3 agar medium, a typical growth was found characterized by different size round colonies, wooly mycelium and pink pigmentation on the top produced at the time of sporulation and red pigment produced through the medium (possibly produce on vegetative mycelium). Microscopic strain characteristics allowed to confirm Streptomyces genus identity, thanks to gram-positive non-fragmented mycelium visualization with few spores.
Regarding C. gloeosporioides isolates, it was necessary to confirm their identity through phenotypic characterization. From a pure culture of the microorganism, it was possible to observe hyaline, septate and branched mycelium in base and, hyaline and ellipsoid conidia with no more of one septum. In PDA medium, the isolate showed a typical characteristic radial growth, brown-gray mycelium formation, and low orange pigmentation. Pathogenicity assays were carried out on natural rubber leaf tissue by molecular characterization laboratory research staff (non-showed data). This allowed confirming isolate virulence.
To confirm Streptomyces 5.1 phenotype as a biocontrol agent against C. gloeosporioides a growth inhibition assay was performed using wildtype strain. The obtained results were compared with Vinchira-Villarraga et al. (2017) reports, finding germination inhibition percentages of 59.8 ± 2.3%, which were a non-statistical differential in comparison to 61.1% obtain in previous group research.
Antifungal activity screening in Streptomyces 5.1 mutants
Aiming the obtention of a library of mutants by the antifungal bacterium Streptomyces 5.1. A random mutagenesis protocol was established by controlled exposure to ultraviolet light. To obtain the mutants library, a 105 UFC mL-1 suspension of Streptomyces 5.1 (preserved in 20% glycerol). To obtain the mutants of Streptomyces 5.1 a 1 mL of the bacterial suspension was placed inside a 9 cm petri dish using the cover with direct exposure to ultraviolet light (about 15 cm from the ultraviolet light bulb) in constant agitation (90 rpm) in three independent essays. After ultraviolet exposure, a counting in plate of the resulting colonies was performed with the aim of determination the survival rate, which was between 0,01 - 1%.
For antifungal activity screening, it was carried out three exposure ultraviolet lights essays starting from three individual vials from wildtype strain work bank. From this process, it was recuperated 300 mutants which were purified and cultured in liquid LB medium. However, from 300 original isolates, just 32 were viable in liquid cultures (including wildtype strain) and the second subculture in a solid medium.
From these 32 mutants, it was possible to observe that some mutants presented different phenotypic characteristics to the wildtype strain. Most evident changes were i) pigmentation differences in colonies, which presented some variations from pink wildtype strain to orange color like NP2 mutant (Figure 1), and ii) the absence of sporulation in the case NP1 and NP2 mutants. Besides of phenotypic diversity between the obtained mutants, pigmentation changes and sporulation absence in some of the mutants, allowed us to suggest that the mutagenesis process induced by ultraviolet light was successful, as proposed by Brash (2015).
This type of UV radiation effect was described by Khaliq et al. (2009), with Streptomyces fradiae NRRL-2702 strain. There is described the answer after 120 s to 6 cm distance from light source, obtaining survival rates were among 5 - 8% and allowed to obtain three different morphotypes to the non-exposed strain (Khaliq et al., 2009).
Once 32 Streptomyces 5.1 mutants were selected for evaluation, biological activity assays were carried out in the presence of C. gloeosporiodes with the aim of determinating its behavior in terms of antifungal activity after ultraviolet light exposure. As is shown in Figure 1 and 2, the screening results show that 18 mutants do not have any significant differences in comparison to the wildtype strain and were, therefore, discard from further analysis. Two mutants (P20 and P21) present a significant reduction in their antifungal activity. Nevertheless, this feature was related to other observed conditions including colony growth-rate; that was lower in these two isolates in comparison to wildtype strain.
Figure 1.
Biological activity assays between Streptomyces 5.1 enhanced and null mutants. Production of antifungal compounds by mutants of the bacterium Streptomyces 5.1 for the control of the phytopathogenic fungus Colletotrichum gloeosporioides, a) non-producer mutants (NP) and enhanced (HP), b) producer mutants (P), c) essay scheme.

Figure 2.
Inhibition radius of Streptomyces 5.1 mutants on in vitro tests against Colletotrichum gloeosporioides. Average values of halos are presented in mm ± standard deviation of three replicates per evaluated mutant.
The antifungal activity of Streptomyces 5.1 as actinomycete is justified due to the different action mechanisms for fungal phytopathogens control on in vitro conditions like metabolic compounds production or bioactive agents like antibiotics with diffusible capacity in the medium, siderophores and volatile metabolites like cyanhydric acid and lytic enzymes production (Gopalakrishnan et al., 2011). Furthermore, it was possible to recognize Streptomyces spp. bacteria grow in a period of 5 - 7 days at 28°C and during the mycelial stage, there is secondary metabolites production. The approximated time of strain to metabolites production was related to the production of the pigments, which were released to the medium (Khaliq et al., 2009). This is related to obtained results because the presence of orange pigmentation colonies was linked with the loss of antifungal activity. By contrast, all those with red-pink pigmentation presented antifungal activity against C. gloeosporioides, which coincides with Haq and Daud (2005).
These results allow proposing the hypothesis of bioactive metabolites production in Streptomyces 5.1 is related to the sporulation process and pigments biosynthesis. This hypothesis already has been posed in Streptomyces genus, due to the complex differential process in known in these bacteria.
Generation and evaluation of genomic profiles by Rep-PCR
Once obtained and classified mutants of Streptomyces 5.1, the DNA extractions were done, following the protocol presented at methodology. The integrity of the obtained DNA was evaluated through a 0,8%, and its concentration was determined and adjusted in a range of 50 - 80 ng µL-1 in the different samples.
The electrophoretic profiles of each mutant and the wildtype strain were obtained by amplification with ERIC-PCR primers. By allowing the identification of genomic profile differences between the wildtype strain (WT), enhanced mutant (P1), and the null mutants (without antifungal activity) (NP1-NP11), which can be associated to the expression of the phenotypic traits (Figure 3).

Figure 3.
BOX-PCR DNA fingerprint in Streptomyces mutants 5.1. Evaluation of differential profiles between the wildtype strain (WT), the enhanced mutant (HP) and the 11 null mutants (NP), using as a positive control the genomic of Clostridium acetobutylicum and as a negative control the mixture of reagent with water in the place of DNA.
Likewise, it was possible to recognize that generated damages or changes in Streptomyces 5.1 are due to its vulnerability to wavelengths ultraviolet light of 254 nanometers, because this represents the wavelengths maximum absorption of the molecule of deoxyribonucleic acid. To cell level, the ultraviolet rays are absorbed by nucleic acids which leads to the formation of pyrimidine dimers and other dangerous products. The formation of pyrimidine dimers coincides with changes in double-stranded helix structure, cell mutation, and finally the dead (Howard, 1994).
Previous reports have shown that BOX-PCR as a repetitive fingerprinting technique has allowed the detection of genomic differences between strains and pathogens such as Xanthomonas spp. and Pseudomonas spp., which have not been determined by other classification methods (Louws, Fulbright, Stephens, & Bruijn, 1994). This method has been also employed to demonstrate genomic diversity between different strains of the sugar cane pathogens Xanthomonas albilineans, of different serotypes and geographical origins and evaluate the diversity different strains of Paenibacillus larvae in North America, as a potential honeybee pathogen (Krongdang, Evans, Pettis, & Chantawannakul, 2017).
In this research, the number of obtained bands on each profile corresponding to the wildtype or control, and the mutants of Streptomyces 5.1 was measured, obtaining a range from 18 to 21 bands. From these values, it was made a dendrogram (Figure 4) using the software NTSYSpc ver. 2.2, from a similarity matrix, using the Sørensen-Dice index and cluster analysis by UPGMA.
The dendrogram allowed to establish that using BOX-PCR, the enhanced mutants was the one who presented less genomic changes on its fingerprint concerning the wildtype strain. Likewise, the differences between null mutants were more, finding seven mutants with the same amount of bands (under 19 bands) inside the genomic profile (SNP4, SNP5, SNP6, SNP7, SNP8, SNP9, SNP10) and the SNP2 was the mutants with the greatest number of changes (about 22 bands) with the phenotype and secondary metabolites of enhanced mutant, it is necessary to know the DNA sequence of the fragments.

Figure 4.
Streptomyces dendrogram 5.1. Control grouping and enhanced, and null mutants carried out with the NTSYSpc program, see. 2.2.
Conclusion
Ultraviolet light exposure as a random mutagenesis methodology and Rep-PCR analyses in Streptomyces 5.1 allowed verifying its metabolic activity against Colletotrichum gloeosporioides under in vitro conditions, by comparing wildtype strain to obtained mutants. Making it possible to associate Streptomyces 5.1 phenotypical changes as sporulation, and pigment production, with its activity as a biological control agent, which could be related with changes inside the genome. In addition, the antifungal activity of Streptomyces 5.1 is of great interest to the agricultural industry, due to the high potential to reduce the incidence and effects of plant diseases on crops.
References
Bloemberg, G. V., & Lugtenberg, B. J. (2001). Molecular basis of plant growth promotion and biocontrol by rhizobacteria. Current Opinion in Plant Biology, 4(4), 343-350. doi: 10.1016/S1369-5266(00)00183-7
Brash, D. E. (2015). UV signature mutations. Photochemistry and Photobiology, 91(1), 15-26.
Brown, S. A., Davis, J. A., & Ritchter, A. R. (2012). Efficacy of foliar insecticides on eggs of Nezara viridula (Hemiptera: Pentatomidae). Florida Entomologist, 95(4), 1182-1186. doi: 10.1653/024.095.0449
Cai, Z. Y., Li, J. Z., He, M. X., Xiao, C. Y., & Zhang, C. X. (2009). The effect of three hot fogging concentrates on Colletotrichum leaf fall of rubber tree in rubber plantation. Journal of Agricultural Science and Technology, 32, 10-11.
Cuéllar, A. S., & León, C. H. R. (2011). Ampliación de la base genética de caucho natural con proyección para la Amazonia colombiana: fase de evaluación en periodo improductivo a gran escala. Leticia, CO: Instituto Amazónico de Investigaciones-Sinchi.
Garon, D., Richard, E., Sage, L., Bouchart, V., Pottier, D., & Lebailly, P. (2006). Mycoflora and multimycotoxin detection in corn silage: experimental study. Journal of Agricultural and Food Chemistry, 54(9), 3479-3484. doi: 10.1021/jf060179i
Gopalakrishnan, S., Pande, S., Sharna, M., Humayun, P., Kiran, B. K., Sandeep, D., & Rupela, O. (2011). Evaluation of actinomycete isolates obtained from herbal vermicompost for the biological control of Fusarium wilt of chickpea. Crop Protection, 30(8), 1070-1078. doi: 0.1016/j.cropro.2011.03.006
Guyot, J., Omanda, E. N., Ndoutoume, A., Otsaghe, A.-A. M., Enjalric, F., & Assoumou, H.-G. N. (2001). Effect of controlling Colletotrichum leaf fall of rubber tree on epidemic development and rubber production. Crop Protection, 20(7), 581-590. doi: 10.1016/S0261-2194(01)00027-8
Haq, P. B., & Daud, D. A. (2005). Process of mycelial dry weight calculation for citric acid. Journal of Biotechnology, 9, 31-35.
Hibbing, M. E., Fuqua, C., Parsek, M. R., & Peterson, S. B. (2010). Bacterial competition: surviving and thriving in the microbial jungle. Nature Reviews Microbiology, 8(1), 15-25. doi: 10.1038/nrmicro2259
Howard, B. J. (1994). Clinical and pathogenic microbiology (2nd ed.). St. Louis, MO: Mosby.
Khaliq, S., Akhtar, K., Ghauri, M., Iqbal, R., Khalid, A., & Muddassar, M. (2009). Change in colony morphology and kinetics of tylosin production after UV and gamma irradiation mutagenesis of Streptomyces fradiae NRRL-2702. Microbiological Research, 164(4), 469-477. doi: 10.1016/j.micres.2007.02.005
Korbekandi, H., Darkhal, P., Hojati, Z., Abedi, D., Hamedi, J., & Pourhosein, M. (2010). Overproduction of clavulanic acid by UV mutagenesis of Streptomyces clavuligerus. Iranian Journal of Pharmaceutical Research, 9(2), 177-181. PMID: 24363725
Krongdang, S., Evans, J. D., Pettis, J. S., & Chantawannakul, P. (2017). Multilocus sequence typing, biochemical and antibiotic resistance characterizations reveal diversity of North American strains of the honeybee pathogen Paenibacillus larvae. PLos One, 12(5), e0176831. doi: 10.1371/journal.pone.0176831
Lieberei, R. (2007). South american leaf blight of the rubber tree (Hevea spp.): new steps in plant domestication using physiological features and molecular markers. Annals of Botany, 100(6), 1125-1142. doi: 10.1093/aob/mcm133
Louws, F. J., Fulbright, D. W., Stephens, C. T., & Bruijn, F. J. (1994). Specific genomic fingerprints of phytopathogenic Xanthomonas and Pseudomonas pathovars and strains generated with repetitive sequences and PCR. Applied and Environmental Microbiology, 60(7), 2286-2295. doi: 10.1128/AEM.60.7.2286-2295.1994
Malathum, K., Singh, K. V., Weinstock, G. M., & Murray, B. E. (1998). Repetitive sequence-based PCR versus pulsed-field gel electrophoresis for typing of Enterococcus faecalis at the subspecies level. Journal of Clinical Microbiology, 36(1), 211-215. doi: 10.1128/JCM.36.1.211-215.1998
Nandakuma, R., Shahjahan, A. K. M., Yuan, X. L., Dickstein, E. R., Groth, D. E., Clark, C. A., ... Rush, M. C. (2009). Burkholderia glumae and B. gladioli cause bacterial panicle blight in rice in the southern United States. Plant Disease, 93(9), 896-905. doi: 10.1094/PDIS-93-9-0896
Serrano-Carreón, L., & Galindo-Fentanes, E. (2007). Control biológico de organismos fitopatógenos: un reto multidisciplinario. Ciencia, 58(1), 77-88.
Stirling, D. (2003). DNA extraction from fungi, yeast, and bacteria. In J. M. S. Bartlett & D. Stirling (Eds.), PCR Protocols. Methods in molecular biology™ (Vol. 226, p. 53-54). Humana Press. doi: 10.1385/1-59259-384-4:53
Suárez-Moreno, Z. R., Vinchira-Villarraga, D. M., Vergara-Morales, D. I., Castellanos, L., Ramos, F. A., Guarnaccia, C., ... Moreno-Sarmiento, N. (2019). Plant-growth promotion and biocontrol properties of three Streptomyces spp. isolates to control bacterial rice pathogens. Frontiers in Microbiology, 10(290). doi: 10.3389/fmicb.2019.00290
Trindade, D. R., & Furtado, E. L. (2005). Doenças da seringueira. In H. Himati, L. Amorim, A. Bergamim Filho, L. E. A. Camargo, & J. A. M. Rezende (Org.), Manual de fitopatologia. Volume 2: doenças das plantas cultivadas (4a. ed., p. 629-641). São Paulo, SP: Agronômica Ceres Ltda.
Vaidya, R. J., Shah, I. M., Vyas, P. R., & Chhatpar, H. S. (2001). Production of chitinase and its optimization from a novel isolate Alcaligenes xylosoxydans: potential in antifungal biocontrol. World Journal of Microbiology and Biotechnology, 17, 691-696.
Versalovic, J., Koeuth, T., & Lupski, J. R. (1991). Distribution of repetitive DNA sequences in eubacteria and application to fingerprinting of bacterial genomes. Nucleic Acids Research, 19(24), 6823-6831. doi: 10.1093/nar/19.24.6823
Vinchira-Villarraga, D. M., Tibambre, M. E. M., Romero, I. A. G., Suarez-Moreno, Z. R., & Moreno-Sarmiento, N. (2017). Evaluation of biocontrol properties of Streptomyces spp. isolates against phytopathogenic fungi Colletotrichum gloeosporioides and Microcyclus ulei. African Journal of Microbiology Research, 11(5), 141-154. doi: 10.5897/AJMR2016.8270
Vurukonda, S. S. K. P., Giovanardi, D., & Stefani, E. (2018). Plant growth promoting and biocontrol activity of Streptomyces spp. as endophytes. International Journal of Molecular Sciences, 19(4), 952. doi: 10.3390/ijms19040952
White, T., Bruns, T, Lee, S., & Taylor, J. (1990). Amplification and direct sequencing of fungal ribosomal RNA genes for phylogenetics. In M. A. Innis, D. H. Gelfand, J. J. Sninsky, & T. J. White (Eds.), PCR Protocols: A guide to methods and applications (p. 315-322). New York: Academic Press. doi: 10.1016/B978-0-12-372180-8.50042-1
Yagüe, P., López-García, M. T., Rioseras, B., Sánchez, J., & Manteca, A. (2012). New insights on the development of Streptomyces and their relationships with secondary metabolite production. Current Trends in Microbiology, 8, 65-73. PMID: 24707121
Notas de autor
cdcastanedan@gmail.com